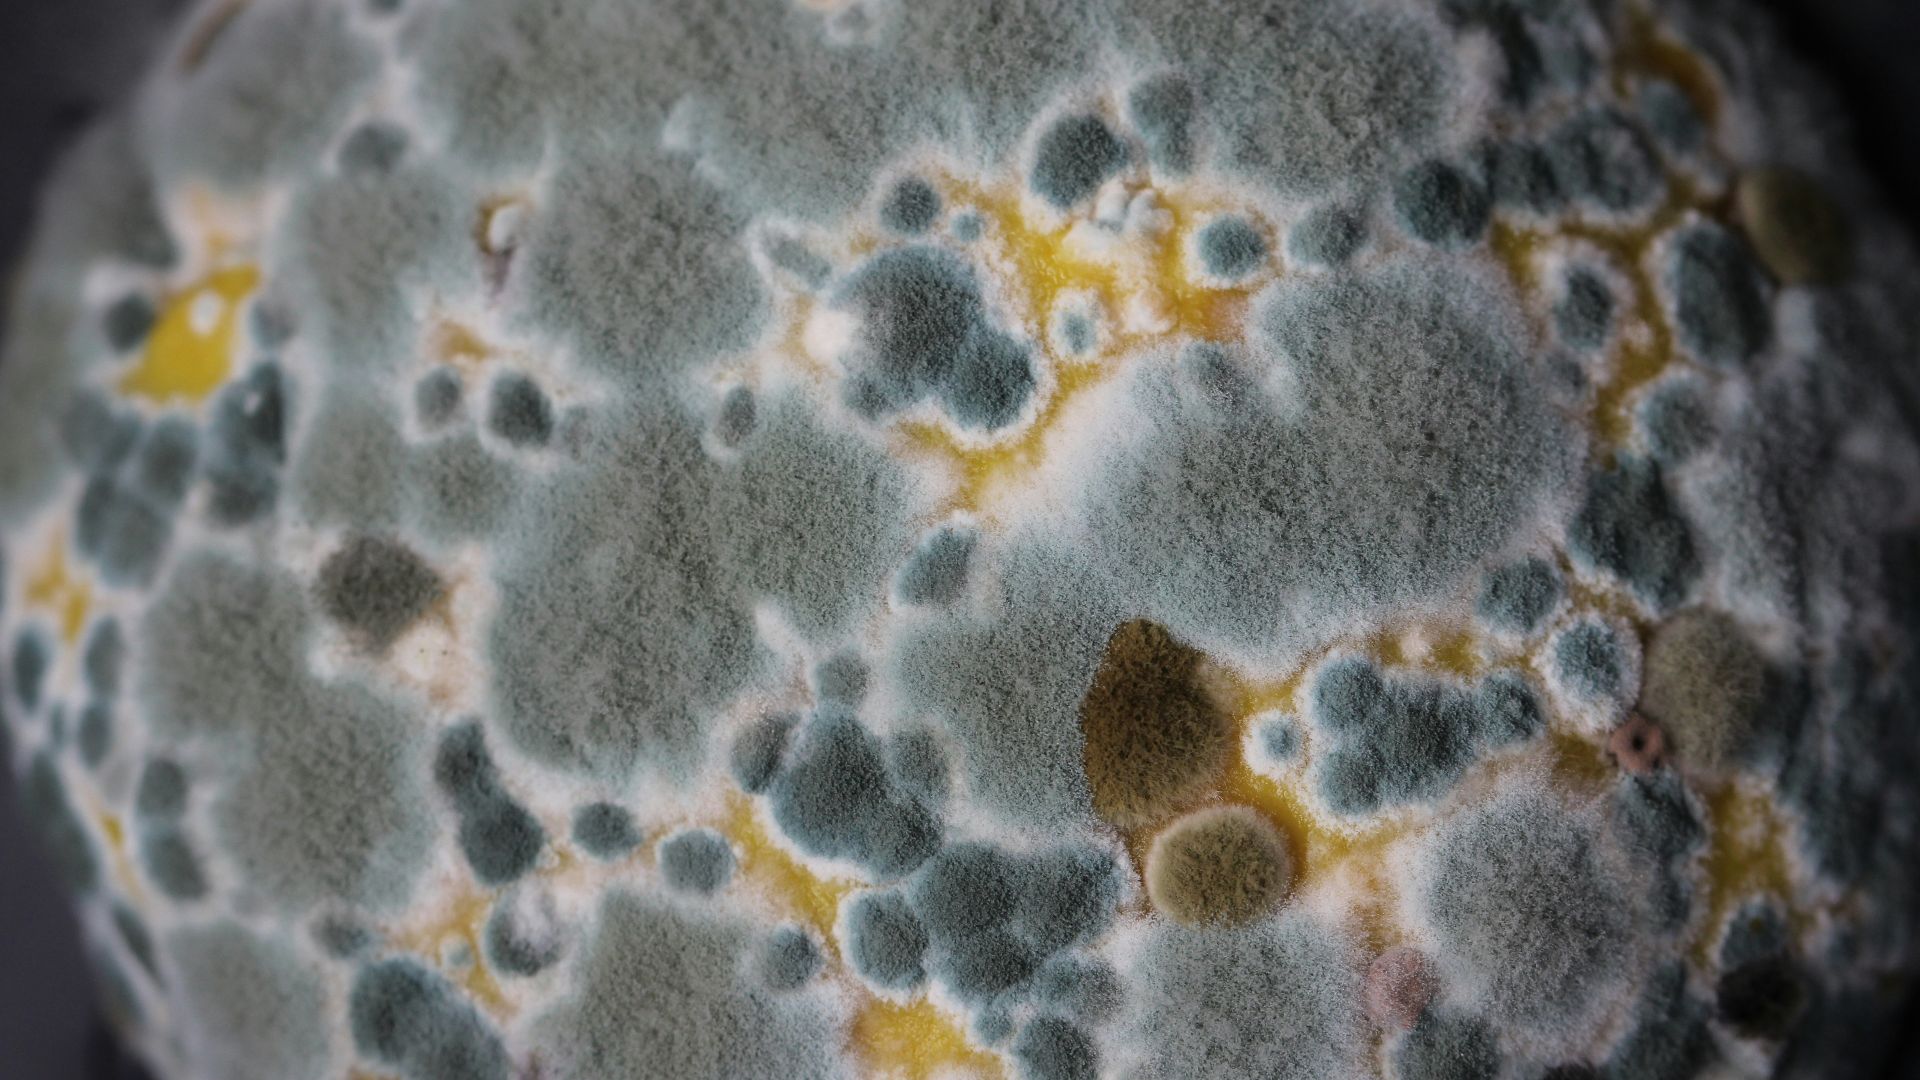
white and blue floral textile

What Could Be Lurking in Your Food?
Pumpkin juice contaminated with botulism. Small stones found in chocolate bars. Ice cream mixed with metal fragments. As frightening as these sound, they're just a few examples of recent food recalls in the US. But what are the top causes of products being sent back—and what can you do to keep yourself safe?
1. Allergen Contamination
Allergen contamination is one of the leading causes of food recalls. In fact, it accounts for nearly 40% of all recalls in the US over the past several years. When products that come into contact with major allergens, like soy, peanut, and milk, aren't declared, it could inadvertently trigger severe reactions in consumers, which is what makes this type of cross-contamination so dangerous.
2. Bacterial Contamination
Bacterial contamination, where foods contain harmful pathogens like Listeria, E. coli, and Salmonella, accounts for roughly 22% of all recalls in the US in recent years. When consumed, these microorganisms can cause extreme symptoms, gastrointestinal issues, and even death.
3. Foreign Material Contamination
Sometimes, the food you buy may even inadvertently be contaminated with foreign materials, such as glass, plastic, wood splinters, or metal, which could be introduced to products during the packaging process. Not only could consuming affected items pose health risks, but they could even severely injure consumers.
4. Environmental Contamination
Contamination from water, soil, or air could also spoil your products, which can happen if food comes into contact with harmful pathogens from contaminated water sources or toxins released into the environment. The aftermath of natural disasters, like floods, can make this type of contamination more likely.
5. Improper Storage or Spoilage
Poor storage and handling of food can lead to bacterial growth and spoilage. For example, products that are stored at incorrect temperatures may create an environment where pathogens like Listeria can thrive and multiply. And while spoilage accounts for only roughly 2% of all recalls, it's still a cause for concern.
6. Undeclared Ingredients
As mentioned previously, allergen contamination happens when products come into contact with major allergens but go unlisted on labels, which can trigger severe reactions in consumers. This may sometimes happen due to formulation changes. Additives, like food colorants, could also be missed.
7. Unapproved Additives
The US Food and Drug Administration has strict regulations on what additives are allowed in products. If it's found later on that certain foods contain substances that weren't approved, these products will then need to be recalled so that they can be reformulated for safe consumption.
8. Mislabeling
Undeclared ingredients technically go under mislabeling, but sometimes, errors can go further than that. Some products may go through a mix-up and be fitted with completely different labels that don't list the correct ingredients. While mislabeling accounts for less than 10% of recalls, it's still a major concern, especially when it comes to missing allergens.
9. Pesticide Residue
Pesticides are regularly used in agriculture to protect crops, but sometimes, traces could be left behind which remain on the final product. While this is normally strictly regulated by the US Environmental Protection Agency to prevent these kinds of occurrences, affected items may sometimes still slip through the cracks and prompt a recall after further testing.
Shad Arefin Sanchoy on Unsplash
10. Lead Contamination
Lead contamination accounts for less than 2% of all recalls, but that doesn't make it less scary. Just the fact that it still happens is frightening enough. Consuming lead-contaminated food can pose severe health risks, such as developmental delays and irreversible brain damage.
So, what are some ways to protect yourself from food contamination? Read on for 10 tips.
Hi-Res Images of Chemical Elements on Wikimedia
1. Wash Your Hands
One of the easiest ways you can prevent food contamination from occurring is by making sure your hands are clean before you handle, prep, or cook food. Bacteria can easily transfer over to the produce and proteins you're handling, so it's important to make sure your hands are squeaky clean. You might even prefer wearing gloves.
2. Wash Fresh Produce—But Not Meat
The food you buy goes through a whole journey before it ends up in your supermarket, and that means it could be contaminated with countless bacteria by the time you decide to eat it. To prevent yourself from getting sick, wash your produce with water before cutting, cooking, or consuming it. However, do not wash meat, poultry, or eggs, as this can actually spread germs and increase the risk of contamination.
3. Check Expiration Date
While most products you buy have a sell-by date (meaning you shouldn't be sold anything that's already expired), you should still double-check on your own. Sometimes, items nearing their expiry date might get a markdown, so make sure to thoroughly examine your produce before purchasing.
4. Use Separate Cutting Boards for Produce & Proteins
When preparing your produce and proteins, use separate cutting boards and knives. You don't want to contaminate ready-to-eat fruits and veggies with raw meat. To make it easier to remember which cutting board is for which, label them clearly.
5. Other Sources of Cross-Contamination
There are other ways cross-contamination can occur as well, other than just using the same cutting board or knives. Using the same plate or container to store raw and cooked meat is one way, as is handling these proteins with the same utensils without first washing them with warm, soapy water. You should also never reuse the marinade for raw meat on cooked meat.
Pixelme Stock Photography on Pexels
6. Store Your Groceries Properly
It's important to store your groceries properly as well, and at the recommended temperatures. Keep fruits, veggies, and meat separate in the fridge so that your ready-to-eat goods are placed away from raw protein. Another tip: always cover and store meat on the bottom shelf so it won't drip and contaminate other foods.
7. Cook Foods Thoroughly
This should go without saying, but make sure to cook your food thoroughly. Heat is what kills bacteria, and not cooking your protein all the way leaves room for germs to continue thriving. It may help to use a thermometer when cooking. Proteins from pork to poultry should reach an internal temperature of at least 160-165°F, and steaks should be cooked to around 145°F.
8. Keep Surfaces, Equipment, & Appliances Clean
When working with raw meat, you should keep your hands and everything your protein touches clean at all times. This means scrubbing down cutting boards, knives, utensils, equipment, and appliances before and after you cook to prevent cross-contamination.
9. Separate Produce from Proteins When Shopping
It's not enough to just separate your produce from your proteins in the fridge—you should already be keeping them away from each other when shopping. Place produce and proteins into plastic bags before placing them into your cart, then bag them separately at checkout. This helps ensure no cross-contamination occurs before you even reach home.
10. Keep an Eye Out for Food Recall Notices
Keep a keen eye out for food recalls. If you've consumed something that's been recalled or you purchased an affected item, follow the notice to see exactly what you should do. Never ignore recalls and the manufacturer's instructions, or do anything that could put you or others around you in danger.
KEEP ON READING
If You Never Wash Your Water Bottle, Read This